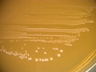
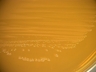
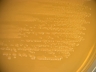

Accessioned in 1982.
=ATCC 14931 =BCRC 12190 =CCUG 30138 =CECT 4007 =CIP 102980 =DSM 20052 =IFO 15885 =KCTC 3112 =LMG 6902 =NBRC 15885 =NCDO 1750 =NCIMB 11840 =NRIC 1752 =NRRL B-4524 =VTT E-93489.
Lactobacillus fermentum.
Type strain [013,12937].
Medium: 1; Temperature: 37°C; Rehydration fluid: 663. more information + Full / Short version of the cataloguepage top

open link in new window

open link in new window

Instructions for an order
Instructions for an order